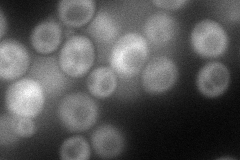
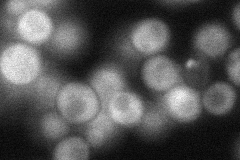
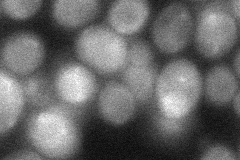
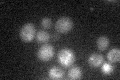

View description
Cytoplasmic pre-60S factor; required for the correct recycling of shuttling factors Alb1, Arx1 and Tif6 at the end of the ribosomal large subunit biogenesis; involved in bud growth in the mitotic signaling network
Localization:
Intensity:
Fold change:
Significance:
-
C’ GFP library in SD

below threshold15.37 -
N' NOP1pr-GFP in SD
cytosol79.0825 -
N' TEF2pr-mCherry in SD

cytosol52.1731 -
N' NATIVEpr-GFP in SD
cytosol58.7644 -
N' TEF2pr-VC and Cyto-VN in SD
cytosol38.3075 -
C’ GFP library in SD+DTT

cytosol17.341.12No -
C’ GFP library in SD+H2O2

cytosol18.011.17No -
C’ GFP library in Starvation Media
cytosol28.471.85No -
C’ GFP library on the background of Pup2-DaMP

below threshold -
C’ GFP library on the background of CCT mutant

below threshold16.61961.08057No
